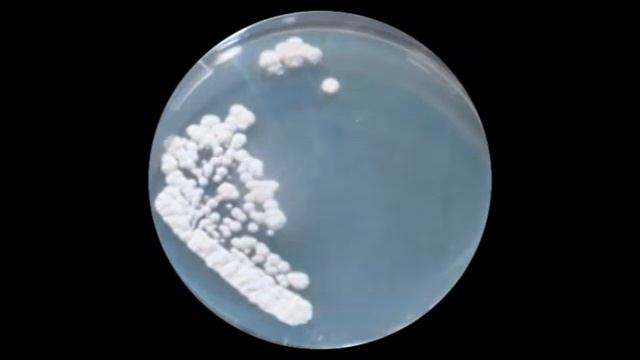
Penicillium смотреть онлайн

Автор / Канал: Грибы: зов природного богатства

Amarula Bandhu Mitrula Sangham 3rd conference, Hyderabad

Отзыв Нины Ивановны про ООО БУРМАСТЕР52 ИЗ 1 САДА

Грибы Верю НОВЫЙ КЛИП 2018

Исправление интро для dimden
![МИКРО [prod. by DooMee] смотреть онлайн МИКРО [prod. by DooMee] смотреть онлайн](https://pic.rtbcdn.ru/video/2025-02-03/b9/1b/b91b2e0763a7f814966a7b9c5cfd0bd3.jpg)
МИКРО [prod. by DooMee]

По грибы #2

В лес за грибами
Penicillium

прогулялся за грибами 2 км и полное ведро

ДУЭЛЬ чизиииикссссса против ПАПЫ ГРИБА

Маринованные шампиньоны.

Авто салон Robocar - китайский автомобиль в Гуанчжоу

§ 4 Текст, речення, слово

Показываю парк Веселка, в Мариуполе.

How I Recover For MAXIMUM Gains & Strength

Gözel Annamuhammedowa - Bohat Pyar Karte (Cover) Turkmen Klip 2018

Рядовой уже не кадет!

кавер:"Ты не такая"-Валентин Стрыкало (от "дыра в сердце")💘

Топ 3 анимации бс

Гриби у сніг. Карпати. Ліс - просто казка!

Шаг за Шагом..(Изгнание когтя) •русская озвучка•#возрадимрукв

Я буду за тебя молиться

Tripping Kosher: Natural Products Expo West 2022 - Los Angeles, CA

Грибы -Тает лёд (HD)
За каждым успешным каналом стоит личность, идея и сотни часов кропотливого труда. Если вы здесь, значит, автор «Грибы: зов природного богатства» уже сумел зацепить ваше внимание своим уникальным стилем или подачей. А мы на RUVIDEO позаботились о том, чтобы вы могли изучить весь архив его работ в максимально комфортных условиях — без лишней суеты и преград.
Почему за работами канала «Грибы: зов природного богатства» так интересно наблюдать? Всё просто: это честный контент, который находит отклик в сердцах зрителей. На нашем ресурсе вы можете смотреть онлайн все видео любимого автора бесплатно и в хорошем качестве. Нам важно, чтобы вы видели каждую деталь и слышали каждый нюанс, поэтому мы используем только стабильные плееры из открытых источников Rutube.
Следите за новинками канала, пересматривайте старые шедевры и открывайте для себя новые грани творчества «Грибы: зов природного богатства». Мы постоянно обновляем ленту, чтобы у вас под рукой всегда были самые свежие выпуски. Никаких сложных регистраций — только вы и творчество, которое вдохновляет. Приятного вам путешествия по миру авторского контента на RUVIDEO!
Видео взято из открытых источников Rutube. Если вы правообладатель, обратитесь к первоисточнику.